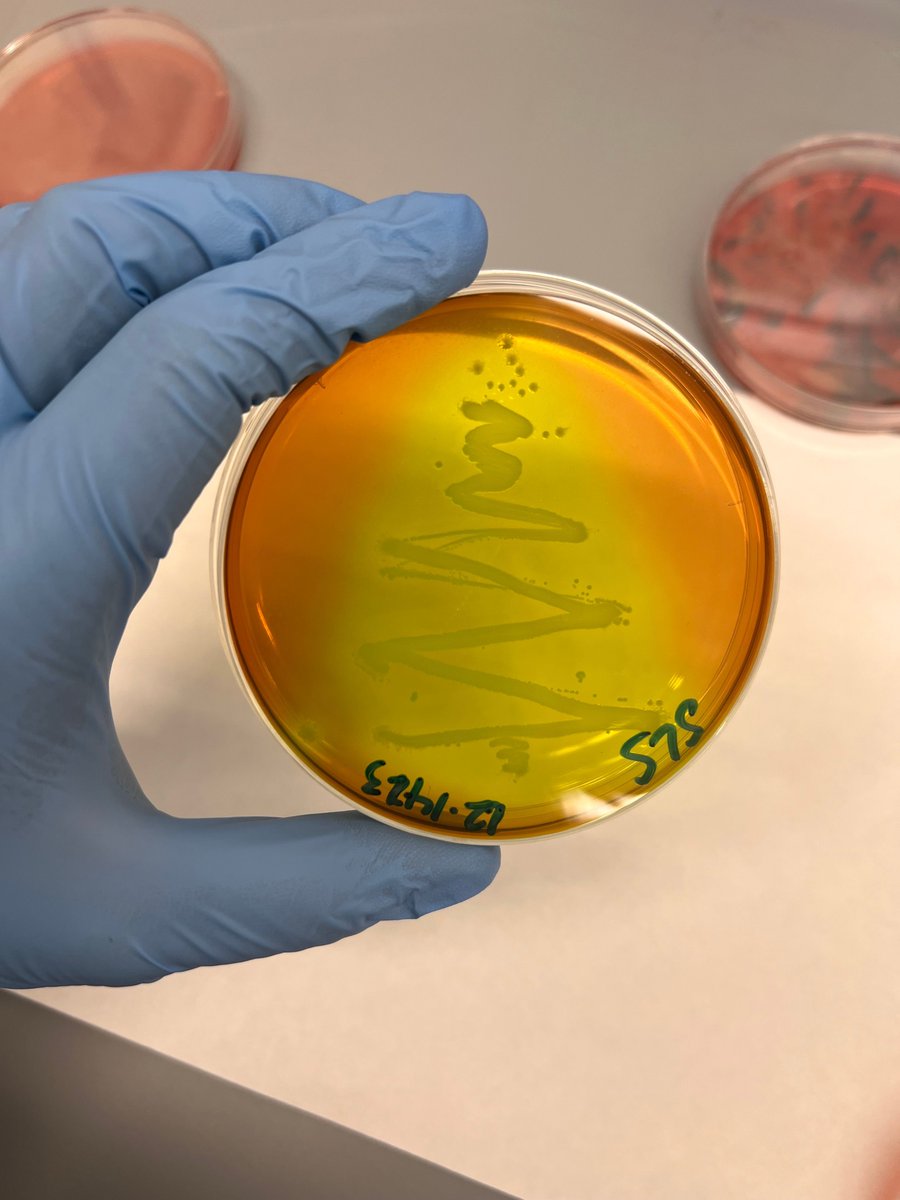
Ganda Lab tweet media

Ganda Lab retweetledi

Kicking off another productive visit at USP in Pirassununga FZEA with a talk on antimicrobial resistance and a workshop about microbiome data analysis! Thanks to @QIAGEN for supporting our efforts through @PSUmBiome collaboration.


English